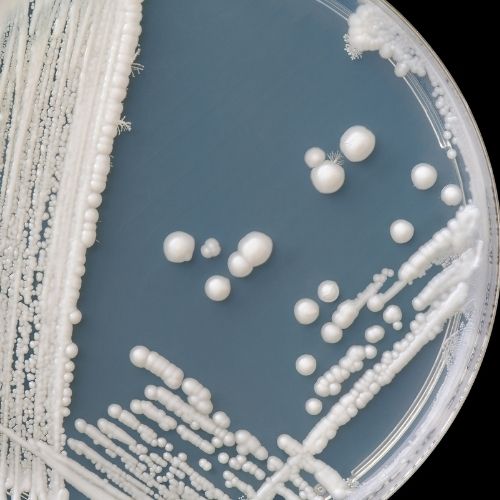

Many people try to treat Candida and fail — not because Candida isn’t the problem, but because the treatment approach is incomplete or out of order.
Read More ->
If you’ve been told you have IBS… then SIBO… then Candida… and you’re confused about which one you actually have — this video will help you finally make sense of it.
Read More ->
Candida often doesn’t show up on tests — and that confuses a lot of people. Candida doesn’t shed consistently, stool tests have limits, and blood tests often miss gut-localized problems.
Read More ->
If you’ve been struggling with IBS for years, it’s not because you’re complicated, broken, or doing something wrong. It’s usually because one or more root causes were missed.
Read More ->
If you follow Peter Attia, you already know modern medicine is reactive—and broken. What most people don’t realize is that the type of systems-based, preventive, metabolic-focused medicine Peter Attia talks about has been practiced for decades by naturopathic doctors.
Read More ->
Everyone wants to cure cancer. But curing a disease requires understanding and addressing its causes.
Read More ->
IgG and IgA food antibody testing is often misunderstood. It’s not a food allergy test—and it’s not something you should interpret on your own.
Read More ->
Many people diagnosed with IBS are actually dealing with an underlying Candida overgrowth. IBS is a description of symptoms — not a cause — and when treatment doesn’t work, something important is often being missed.
Read More ->
If you’ve tried everything for IBS — low FODMAP, probiotics, fiber, SIBO treatment — and you’re still struggling, it’s not your fault.
Read More ->
Most people with Candida don’t just have digestive symptoms. They have symptoms they’d never think are yeast-related.
Read More ->Seattle: 206-264-1111
Los Angeles: 310-319-1500
Our WhatsApp: 206-791-2660
Copyright © 2024 IBS TREATMENT CENTER. All Rights Reserved